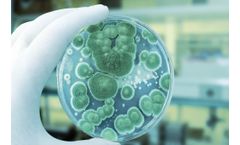
RMBNucleus - Mold Alarm Software

- Home
- Software
Refine by
Rmbnucleus Environmental Software
3 software items found
Manufactured by:Rapid Micro Biosystems, Inc. based inLowell, MASSACHUSETTS (USA)
RMBNucleus™ Mold Alarm allows investigations to begin in as little as one day with automated alerts triggered by detection of molds during the early stages of incubation. ...
Manufactured by:Rapid Micro Biosystems, Inc. based inLowell, MASSACHUSETTS (USA)
RMBNucleus™ 4.0 is the newest software for the Growth Direct® System that provides: Secure support of Windows 10 and SQL Server 2019. Upgraded reporting and auditing in compliance with 21 CFR Part 11. Streamlined recovery, monitoring, and user ...
Manufactured by:Rapid Micro Biosystems, Inc. based inLowell, MASSACHUSETTS (USA)
RMBNucleus™ Central Manager offers system transparency without the need for direct physical access. ...